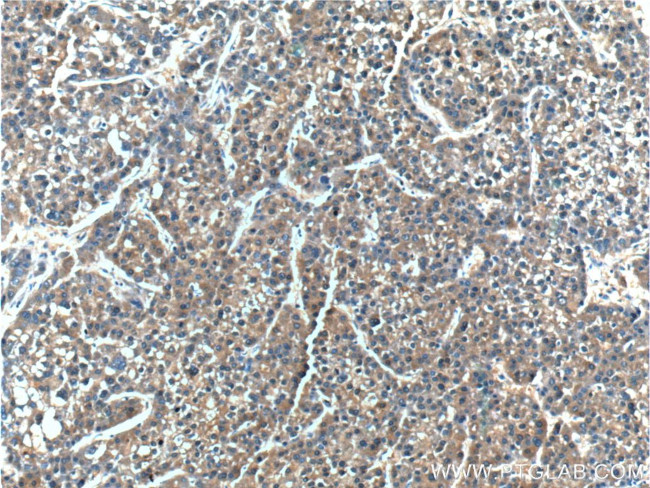
ERLIN2 Antibody in Immunohistochemistry (Paraffin) (IHC (P))

Search
Proteintech
ERLIN2 Polyclonal Antibody
{{$productOrderCtrl.translations['antibody.pdp.commerceCard.promotion.promotions']}}
{{$productOrderCtrl.translations['antibody.pdp.commerceCard.promotion.viewpromo']}}
{{$productOrderCtrl.translations['antibody.pdp.commerceCard.promotion.promocode']}}: {{promo.promoCode}} {{promo.promoTitle}} {{promo.promoDescription}}. {{$productOrderCtrl.translations['antibody.pdp.commerceCard.promotion.learnmore']}}
产品信息
14781-1-AP
种属反应
宿主/亚型
分类
类型
抗原
偶联物
形式
浓度
规格
纯化类型
保存液
内含物
保存条件
运输条件
产品详细信息
Immunogen sequence: VHKIEEGHI GVYYRGGALL TSTSGPGFHL MLPFITSYKS VQTTLQTDEV KNVPCGTSGG VMIYFDRIEV VNFLVPNAVY DIVKNYTADY DKALIFNKIH HELNQFCSVH TLQEVYIELF GKKVSPEHAV LKQGSWNPAS LHCLKPGCLQ GVMVTYGQEM LKNLVLRSWS QRSSWRMLIA MQQDP (23-206 aa encoded by B C067765)
靶标信息
ERLIN2, also named as C8orf2 and SPFH2, is a component of the ERLIN1/ERLIN2 complex which mediates the endoplasmic reticulum-associated degradation (ERAD) of inositol 1, 4, 5-trisphosphate receptors (IP3Rs) such as ITPR1. It promotes sterol-accelerated ERAD of HMGCR probably implicating an AMFR/gp78-containing ubiquitin ligase complex. ERLIN2 is involved in regulation of cellular cholesterol homeostasis by regulation the SREBP signaling pathway. The MW of ERLIN1/ERLIN2 complex is about 70 kDa.
仅用于科研。不用于诊断过程。未经明确授权不得转售。
生物信息学
蛋白别名: Endoplasmic reticulum lipid raft-associated protein 2; endoplasmic reticulum lipid raft-associated protein 2 {ECO:0000250|UniProtKB:Q8BFZ9, ECO:0000312|EMBL:AAI68668.1}; epididymis secretory sperm binding protein; Erlin-2; erlin-2 {ECO:0000250|UniProtKB:Q8BFZ9}; erlin2 {ECO:0000312|EMBL:AAI68668.1, ECO:0000312|RGD:1309010}; HGNC:1356; MGC87072; spastic paraplegia 18 (autosomal dominant); SPFH domain family, member 2; SPFH domain-containing protein 2; SPFH domain-containing protein 2 {ECO:0000250|UniProtKB:Q8BFZ9, ECO:0000312|EMBL:AAI68668.1}; Stomatin-prohibitin-flotillin-HflC/K domain-containing protein 2; stomatin-prohibitin-flotillin-HflC/K domain-containing protein 2 {ECO:0000250|UniProtKB:Q8BFZ9}; unnamed protein product; UNQ2441
基因别名: BC036333; C87251; C8orf2; Erlin-2; ERLIN2; NET32; RGD1309010; SPFH2; SPG18; SPG18A; SPG18B; UNQ2441/PRO5003/PRO9924
UniProt ID: (Human) O94905, (Mouse) Q8BFZ9, (Rat) B5DEH2
Entrez Gene ID: (Human) 11160, (Mouse) 244373, (Rat) 290823